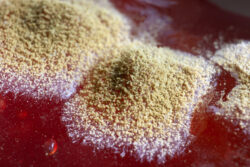
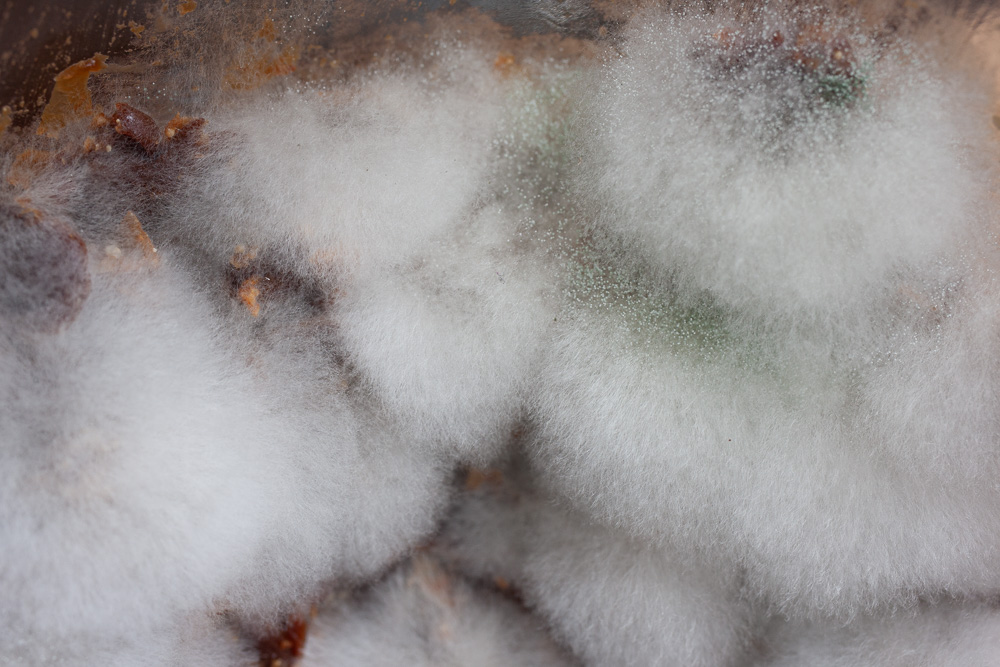

Je to plíseň?
| 25. července 2025 | přečtete za 9 minut
Plíseň. Největší strašák v jídle, nejčastější dotaz při kvašení, všudypřítomná hrozba podlomeného zdraví. Tohle je základní průvodce tím, jak ji poznat, jak jí předcházet, kdy je to ještě v pohodě a kdy už předpisově zpanikařit.
Jak plísně poznat
Plísněmi se souhrnně rozumí vícebuněčné houby tvořící z bílých vláken (hyf) spletitou síť zvanou mycelium, přičemž uzrálé plodnice jsou pouhým okem neviditelné a tvoří se na nich různobarevné spory. Jelikož jsou plodnice miniaturní, říká se těmto houbám mikromycety — na jejich pozorování byste potřebovali lupu nebo mikroskop. Je jich ohromné množství rodů a druhů, nejznámější z praxe jsou třeba rody kropidlák (Aspergillus), štětičkovec (Penicillium) nebo plíseň (Mucor) nebo plíseň (Botrytis).
U velkých hub (makromycetů) jsou plodnice okem viditelné a s dobrými houbařskými/mykologickým znalostmi dokážeme aspoň několik druhů rozlišit a stanovit tak jejich bezpečnost. U plísní nelze od oka určovat prakticky nic — nelze se opřít o barvu plodnic nebo tvar — všechno to má bílé mycelium a uzrálé spory hrají barvami od bílé, přes žlutou, okrovou, červenou, zelenou, šedou až černou, což také není dobrý znak, protože mnohé druhy tyto vlastnosti sdílejí a naopak jeden druh může hrát více barvami v rámci variet (kodži může být bílá, žlutozelená i khaki).
Pokud narazíte na potravinu, ať už čerstvou nebo fermentovanou, a chcete stanovit, jestli se vůbec bát a začít ji vyhazovat, hledejte tyto základní znaky plísní:
- bílá vlákna mycelia, která drží pohromadě a rozrůstají se všesměrově v kruzích
- tvorba výtrusného prachu (spor) jedné barvy (je-li na místě více barev, jedná se o různé druhy hub)
- soudržnost na mokrých hladinách — když to plave na povrchu jako koláček, jde to sebrat rukou nebo pinzetou a stále to drží pohromadě
- výhradně kyslíkaté prostředí, čili hladiny a povrchy, kudy volně proudil vzduch.

Co není plíseň
Máme od autorit zvnitřněno, že co je plesnivé, to je nebezpečné a náš vnitřní detektor je hystericky vyšponovaný na maximum, takže za plíseň označí všechno, co vypadá na povrchu či pod povrchem jinak než sterilovaný výrobek z obchodu. Není to potřeba, potřeba je vydechnout a podezřelý chuchel nebo sliz řádně poňoupat a podrobit zkoumání. Plíseň není:
- pod vodní hladinou
- mazlavá
- poskládaná ze samostatných buněk
Jakmile tedy povrchový růst není chlupatý, se sporami a jde rozmáznout prstem, jedná se patrně o vrstvičku křísu nebo různé bakteriální mazy a mázdry.









Rizika plísní
Ano, houby jsou velmi účinní rozkladači a vypouští do so svého krmiva nejen trávicí enzymy (což se nám kuchyni hodí), ale jako ochranu před nezvanými hosty někdy i látky, které nám mohou poškozovat zdraví buď akutně (paličkovice nachová), anebo dlouhodobě při soustavné a hojné konzumaci (ochratoxiny). Vzhledem k tomu, že mikromycety (plísně) je těžké zařadit do druhu a do variety i za použití pokročilých mykologických metod, přistupuje se univerzálně k zasaženým potravinám dle pravidla „better safe than sorry“ a je doporučeno potravinu zlikvidovat, protože nevíme, jestli houba toxiny vypustila či nikoliv.
Souhlasím, že není vhodné mít jako běžnou součást jídelníčku spontánně a silně zaplísněné potraviny — kávu, ořechy, pečivo, ovoce, zeleninu. Pokud stanoví laboratoř přítomnost ochratoxinů, do pece s tím. O tom, jak je to s bezpečností flíčků na vašich fermentech jsem už psal v článku Fuj, plíseň! a nebudu plýtvat místem v tomto zápisku.
Připomínám však i myšlenku, že každý den děláme svému zdraví mnohem horší věci, než je konzumace misa, na kterém se v průběhu zrání ukázalo kolečko velikosti pětikoruny. Někdo jí zdravě, ale nespí, někdo sportuje, ale užívá drogy, někdo jí, spí, nekouří a nepije, ale zase nesportuje (já). To všechno se děje většinou dlouhodobě a soustavně, protože jde o návyky a pak je malý exces v plísňovém flíčku asi dost nevýznamný.
Kdy vyhazujeme a kdy tolerujeme
Potravinář zodpovědný za bezpečnost vyhazuje vždy a ve výrobě je to tak v pořádku. Doma jsme benevolentnější a pokud jde o fermenty, na kterých se prokazatelně kulatý ostrůvek s výtrusným prachem ukázal, počínáme si intuitivně:
- malý flíček neřešíme, sebereme, vyhodíme, ferment promícháme nebo úplně přeskládáme do čisté nádoby, zamezíme lépe přístupu vzduchu a pokračujeme ve zrání/konzumaci;
- silné zasažení značné části nebo celého povrchu vyhazujeme i s celým fermentem.
Znovu odkážu na zápisek Fuj, plíseň!, kde mám pár argumentů, proč nemusí být u fermentů spontánní zaplísnění tak velký problém, jako u čerstvých potravin (pečivo, zelenina).


Prevence při fermentování či skladování
Mnoho mýtů, nepravd a mylných návodů kolotá mezi lidmi a po internetech a přitom je to tak jednoduché. Vícebuněčné houby (ty s myceliem) jsou organismy, které vyžadují pro svůj život kyslík a množí se sporami, které unáší proudící vzduch. Toto když budeme mít na paměti, dokážeme svoje fermenty před nežádoucím a spontánním zaplísněním neznámým druhy velmi účinně ochránit. Nebudu teď jmenovat sušení, nasolování, mražení a další techniky konzervace, při kterých se sice houby nemnoží, ale mikroorganismy také nefermentují.
Základem je dokonale zamezit přístupu vzduchu k fermentům, které kyslík nepotřebují. Kde neproudí volně vzduch, tam nejsou přinášeny spory hub. Kde není kyslík, tam existující spory nevyklíčí a houba nebude prospívat. Platí to jak pro vícebuněčné vláknité plísně, tak i pro jednobuněčné kvasinky křís.



Ferment, který nehnutě stojí a jeho hladinu omývá proudící vzduch unášející spory hub (a je jich fakt hodně), zplesniví za příhodných podmínek v horizontu jednotek dnů. To se týká i přikrytí ubrouskem nebo plátýnkem, které i když vypadají hustě, tak spory o velikosti jednotek mikrometrů bez potíží propustí. Týká se to i sterilovaných zavařenin, u kterých jste použili staré netěsnící víčko.
Ferment, který nějaký ten kyslík vyžaduje a obsahuje stále ještě cukr (třeba kombucha), je potřeba míchat a nenechat přinášené spory, aby na povrchu vyklíčily a vytvořily mycelium.
Naopak zavádějící a pozornost odvádějící je úzkostná hygiena až sterilita. Pokud nemáte laboratoř s HEPA filtry, kde byste dokázali udržet sterilní prostředí, tak jsou spory plísní úplně všude a umytím nebo sterilizací se jich sice částečně zbavíte, ale když nezamezíte během kvašení/zrání proudění vzduchu přinášejícího spory nové, tak bylo všechno to mytí a píglování úplně k ničemu. V domácnosti pracujte v normální kuchyňské hygieně, nemusíte fermenty zakládat v jednorázových rukavicích a vymývat nádoby lihem, protože se o ty prevíty postará úprava životního prostředí nepodporující jejich růst (bezkyslíkatost ruku v ruce s kyselostí a/nebo alkoholovitostí).
Vyloženě kontraproduktivní je pak omývání kultur (kefírových zrn, kombuchových placek) — nevede k očistě od problémů, ale k odplavování žádoucích organismů, které zajišťují zakyselování a tudíž obranyschopnost kultury. Když kyselost a kyselinotvorné ogranismy odeberete, posouváte se s fermentem do neutrálního pH, které plísním vyhovuje.
Mýty a omyly
Přidám a postupně budu podle potřeby rozšiřovat nejčastější otázky a odpovědi k problematice nežádoucích spontánních plísní, to mám rád. Zase takové menší FAQ.
Bezpečnost plísně se pozná podle barev spor. Když je to bílé, tak je to v pohodě, když je to černé, nejíst! To je gigantický omyl! V mykologii neexistuje žádný univerzální znak jedlosti či jedovatosti! Ani u velkých lesních hub, ani u plísní. Kropidlák černý (Aspergillus niger) produkuje ochratoxiny, ale tempehový kropidlovec drobnovýtrusý (Rhizopus microsporus) je i přes černé spory perfektně jedlý. Barva spor nevypovídá o ničem.
Nesmíte do marmelády nebo kimčchi strkat ocucanou lžíci, pak to zplesniví! Není to tak, v puse nemáte o nic víc či míň spor plísní, než kolik se jich pohybuje v běžném prostředí. Zdrojem infekce je vždycky proudící vzduch a růst podpoří kyslíkaté prostředí vzduchové kapsy ve sklenici.
Nic zplesnivělého by s jíst nemělo, může to být prorostlé skrznaskrz! Žádná pravda není v přírodě univerzální, o houbách platí to samé. Prorostlý může být chleba či jablko, ale kyselé kimčchi nebo miso bude s velkou pravděpodobností zasažené jen povrchově, konkurenční prostředí může houbu omezovat.
Plísně jsou toxické. Žádná pravda není v přírodě univerzální. Některé jsou, ale drtivá většina není. Některé vyrábějí třeba látky na regulaci cholesterolu, jiné zase kyselinu citrónovou.
Z povrchových kvasinek (křísu) se stane plíseň! Nestane, kvasinky jsou jednobuněčné organismy, které mají ve své DNA zakódováno, že jsou jednobuněčné a nikdy se z nich vývojem nestane organismus vícebuněčný. Z kvasinky se nestane plíseň, stejně jako z myši nikdy nevyroste kapybara. Může se ale stát, že vzduch přinese na povrch obojí a co se uchytí, to se uchytí. Klidně plíseň na křísu.
Mně zplesniví všechno! Zde bohužel musíme souhlasit, že v některých prostředích je nálož plísňových spor podstatně větší než v jiných. V suchém pražském paneláku v sedmém patře bude situace úplně jiná než v Keni (zdravíme Monču na tamější české velvyslanectví).
Fuj, nic plesnivýho mi nesmí na talíř! No to je škoda, protože třeba Niva, salám Křemešník, saké, rýžový ocet, poctivá sójovka, tempeh nebo miso jsou velmi dobré a perfektně bezpečné výrobky, do kterých svými enzymy přispěly kulturní plísně. Některé dokonce vhodné k častější konzumaci než jiné, bezplísňové (a teď nemyslím ten salám). Šup do článku Fuj, plíseň!
Používám keramický kvašák s tyčkou a vždycky mi to zplesniví. Protože keramický kvašák je navržený tak, aby v něm všechno zplesnivělo — fouká do něj vzduch dírou kolem té tyčky. Nepoužívejte ho a přečtěte si Potřebné vybavení.

Další čtení
- článek Bez vzduchu s tipy na anaerobní bezkyslíkaté prostředí zamezující růstu spontánních plísní
- článek Křís o neproblematických mázdrách
- článek 1000+1 kombuchových otázek a odpovědí s rozsáhlou fotogalerií problémů i neproblémů, na které se často ptáte

10 komentářů
Nikdy mi nic z fermentů nezplesnivělo. Až doteď!
Na kvašené rybě v rýži. Jedna sklenic v pořádku, ve druhé to pěkně porostlo.
Ze zájmu jsem odstranil vrstvu „kožíšku“ plus cca centimetr materiálu a zaplísnění se ještě jednou zopakovalo. A teď, k mému údivu, se povrch pokryl dokonalým křísem. Zajímavá zkušenost. Takže se chystám to ochutnat.
Mimochodem, křís (alespoň na té rýži z Burong Izda) je naprostá umami bomba!
Nojo, ono to někdy vypadá, že je to zavíčkované a ejhle — stačí promáčknutá hrana víčka nebo ohnutá závitová ouška a už dovnitř fučí. I mně se to někdy stane, sice ne často, ale stane. Holt pracujeme pankově..
Tak jsem to ochutnal a následně snědl (viz. příspěvek výše). Vše bez senzorických změn!
Odvážnému štěstí přeje!
Možná je to blbost, a pošlete mě s tím po zásluze do háje, ale experimentuji teď s ošetřením povrchu jablečným octem (druh není podstatný). Prostě to trochu opláchnu a ocet následně sliji. Premisa je taková, že na krátkou dobu zabrání okyselení růstu případné plísně a pak už si to zkysne celé samo. Samozřejmě že to lze aplikovat na tu rýži. Jinde by to bylo složitější. Záměrně to plísní očkovat asi nebudu, jinak nejsem schopen potvrdit, že to funguje a není to „přání otcem myšlenky“, ale nakonec „Kdo si hraje, nezlobí!“
Ano, proti plísním se snižováním pH bojuje. Je jen otázkou, jestli na povrchu potraviny nedojde k nějakému samovolnému promíchání (Brownův pohyb, kondenzace, osmóza aj.) s existujícími tekutinami a pH zase nestoupne. Řekl bych, že to nebude tak spolehlivé, jako striktní anaerobnost. Pohrávám si i s myšlenkou nucené výměny atmosféry vzduchové kapsy za CO₂ z bombičky.
No ty v..e, tak to mě nenapadlo! Tak to je tedy fakt super nápad.
Co dusík? Léta tím prodlužuji „životnost“ pivu v sudu. Kompresor honí vzduchem, když se to nedopije, odpojím kompresor a z bombičky tam dofouknu dusík. Je to fresh minimálně týden.
No, tak to je fakt nápad!
Asi v pohodě, tyhle plyny se v potravinářství běžně používají jako inertní, aerobní organismy to vypne.
Jejda, lidičky, léta používám ke kvašení zeleniny zavrhovaný keramický kvašák, a to k mé naprosté spokojenosti (jenom jsem vyměnila dřevěnou tyčku za potravinářský plast). To jste mě překvapili…
Kontaminace je jen otázkou času. Kdo to nechá jen chvíli nažvejknout, ten to možná stihne před zaplísněním povrchu. Při volně proudícím vzduchu se to ale dřív nebo později zkazí vždycky. Nechte v tom stát řepu 10 dní v teple a máte deku jak koňskou houni.